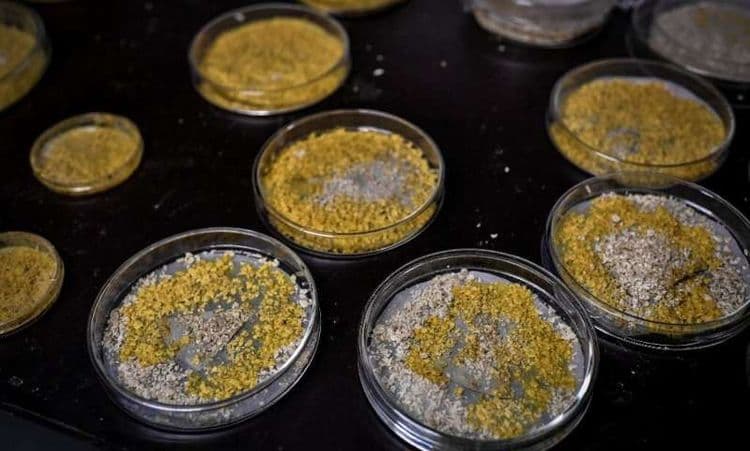

पॅरीसच्या प्राणिसंग्रहालयाने एक विचित्र जीव जगासमोर आणला आहे. या जीवाचं नाव आहे ‘ब्लॉब’. दिसायला हा जीव एखाद्या बुरशीसारखा दिसतो पण तो खरं तर एक प्राणी आहे.
ब्लॉब हा प्राणी खास का आहे याची काही करणं आहेत. ब्लॉबची खाली दिलेली वैशिष्ट्य अविश्वसनीय वाटू शकतात पण ती खरी आहेत.
१. ब्लॉबला पोट आणि डोळे नाहीत, पण तो बघू शकतो आणि अन्न पचवू शकतो.
२. हा दुर्मिळ असा तब्बल ७२० लिंगभेद असलेला जीव आहे.
३. ब्लॉबला पाय नाहीत पण हालचाल जमते.

४. ब्लॉबचे दोन तुकडे केले तर तो २ मिनिटात स्वतःवर उपचार करू शकतो.
५. या प्राण्याला मेंदू नाही पण त्याला गोष्टी शिकता येतात.
६. जर दोन ब्लॉब एकत्र ठेवले तर एकाकडून दुसऱ्याकडे माहितीची देवाणघेवाण होते.

पॅरीस प्राणी संग्रहालयाचे डायरेक्टर ब्रुनो डेव्हिड म्हणतात की ‘हा जीव निसर्गाच्या न उलगडलेल्या रहस्यांपैकी एक आहे.’
१९५८ साली आलेल्या एका सायफाय सिनेमावरून या प्राण्याला ब्लॉब हे नाव मिळालं. सिनेमातला ब्लॉब हा एलियन सदृश्य प्राणी असतो आणि तो वाटेत येणाऱ्या प्रत्येकाला गिळून टाकतो.
मंडळी, या विचित्र आणि गूढ प्राण्यावर सध्या संशोधन केलं जात आहे. सध्या तरी हे एक वैज्ञानिकांना न सुटलेलं कोडं आहे असं म्हणता येईल.






